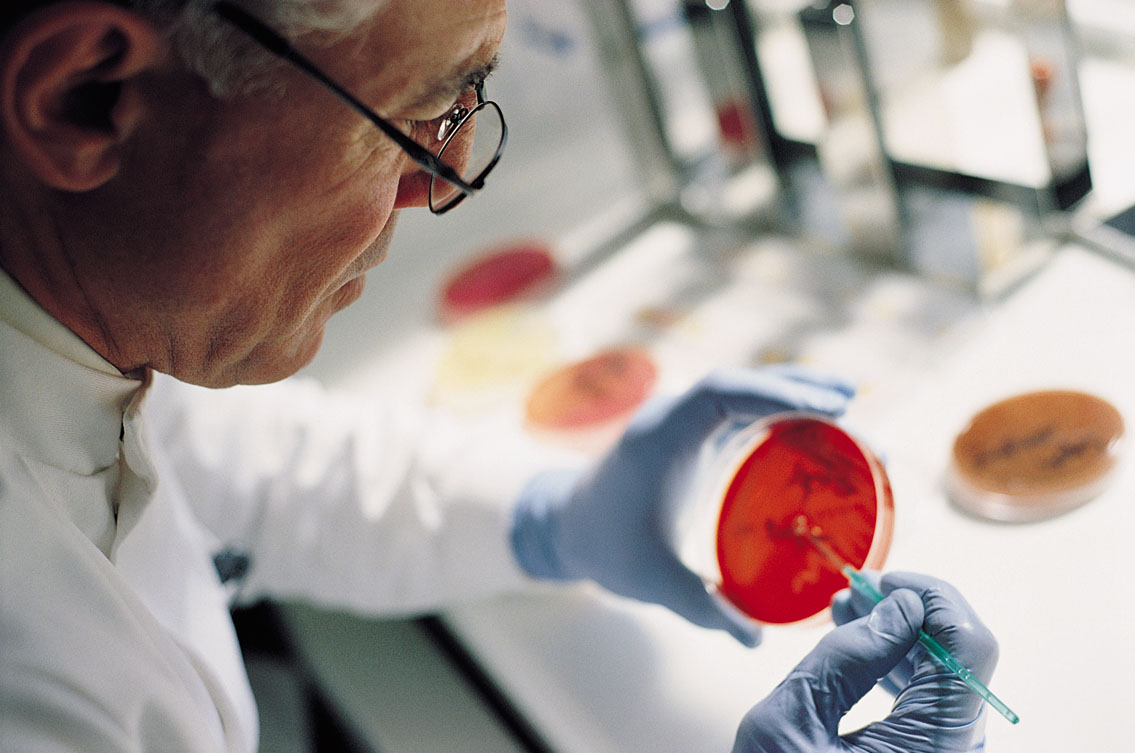

| Медицина и Здоровье. стволовые клетки. ВИЧ. |
![]() |
![]() Словосочетание стволовые клетки сегодня относится к самым обсуждаемым |
ДЛя начало что такое СКК- это стволовые клетки крови- это |
- Во� можности стволовых клеток и� уч� ют ученые всего мир� . |
![]() Медицинские центры, предлагающие лечение стволовыми клетками, легко |
![]() ... тоже получил Нобелевскую премию за исследования в области стволовых… |
![]() |
| Голодание стимулирует способность клеток организма к аутофагии и |

Медицина будущего: человеческие эмбриональные стволовые клетки.

Embryonic Stem Cells Run for President.
![]() Таблетки из стволовых клеток обещают стать новой эрой в медицине. |
![]() |
| ... от тяжелых болезней и верите, что в будущем стволовые клетки п… |

Стволовые клетки из пуповины вылечили ребенка от рака головного мозга
![]() Выпадение волос стволовые клетки лечение - Прическа для красоты. |

Эмбриональные стволовые клетки. Медицина.
![]() |
![]() |
| Клеточная терапия стволовыми клетками. Клуб здоровья и... Московская |

... Центра педиатрии провели уникальную операцию по забору и пересадке …











Комментариев нет:
Отправить комментарий